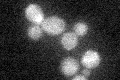
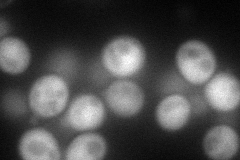
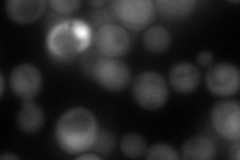
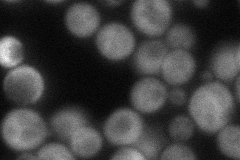
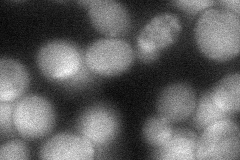

View description
Activating gamma subunit of the AMP-activated Snf1p kinase complex (contains Snf1p and a Sip1p/Sip2p/Gal83p family member); activates glucose-repressed genes, represses glucose-induced genes; role in sporulation, and peroxisome biogenesis
Localization:
Intensity:
Fold change:
Significance:
-
C’ GFP library in SD
cytosol19.5 -
N' NOP1pr-GFP in SD
cytosol102.384 -
N' TEF2pr-mCherry in SD
cytosol179.108 -
N' NATIVEpr-GFP in SD
cytosol68.2206 -
N' TEF2pr-VC and Cyto-VN in SD
cytosol44.6201 -
C’ GFP library in SD+DTT

cytosol17.650.9No -
C’ GFP library in SD+H2O2

cytosol17.170.88No -
C’ GFP library in Starvation Media

cytosol15.380.78No -
C’ GFP library on the background of Pup2-DaMP

cytosol -
C’ GFP library on the background of CCT mutant

cytosol18.22410.934295No
